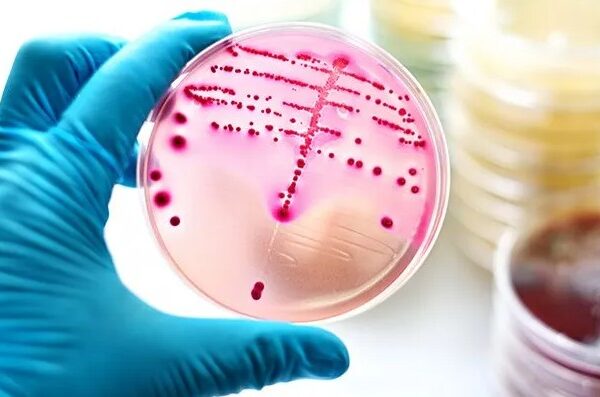

Όρχεις και Επιδιδυμίδες
Όρχεις και επιδιδυμίδες ανατομία
Οι Όρχεις
Οι όρχεις, που αποτελούν τους γεννητικούς αδένες του άνδρα, έχουν σχήμα και μέγεθος καρυδιού, ελαφρώς πεπλατυσμένων εκ του πλαγίου, που μαζί με την όπισθεν αυτών προσκολλημένη επιδιδυμίδα, βρίσκονται μέσα στο σύστοιχο ημιόσχεο(εικ.1).

Εικόνα 1: O Όρχις με τα στοιχεία του σε διατομή
Ο αριστερός όρχις μπορεί να κρέμεται λίγο χαμηλότερα από τον δεξιό. Ο κάθε όρχις είναι ένας σάκος με τέσσερις στοιβάδες, που αντιστοιχούν σε εκείνες του κοιλιακού τοιχώματος. Οι στοιβάδες αυτές, λίγο πριν γεννηθεί το αγόρι, μετατοπίζονται μέσα στο όσχεο ταυτόχρονα με τη μετακίνηση των όρχεων από την κοιλιά.
Το ύψος των όρχεων καθορίζεται από μικρούς μυς, τους κρεμαστήρες μυς. Η θέση τους μπορεί, επίσης, να αλλάξει και ανάλογα με την ένταση της σεξουαλικής διέγερσης του άνδρα, τα συναισθήματά του και τη θερμοκρασία του οσχέου.
Τα σπερματοζωάρια, για να αναπτυχθούν φυσιολογικά, πρέπει να παράγονται σε μία θερμοκρασία δύο με τρεις βαθμούς χαμηλότερη από εκείνη του σώματος. Γι’ αυτό, άλλωστε, οι όρχεις βρίσκονται “έξω” από το σώμα.
Κάθε ένας όρχις (testis) λοιπόν ,περιβάλλεται από τον ινώδη χιτώνα του (tunica albuginea), ο οποίος στην άνω οπίσθια επιφάνεια σχηματίζει μία πάχυνση, το μεσόρχιον (mediastinum), από το οποίο ξεκινούν ινώδη διαφράγματα και διαχωρίζουν το παρέγχυμα του σε 250 περίπου λόβια.
Κάθε λόβιο περιέχει 1-4 σπερματικά σωληνάρια (semineferous tubules), τα οποία συγκλείνουν προς το μεσόρχιο, σχηματίζοντας το δίκτυο του Haller. Από εκεί ξεκινούν 12-15 ευθέα σωληνάρια, που εκβάλλουν στην επιδιδυμίδα και απάγουν τα σπερματοζωάρια προς τον πόρο της. Κ
άθε σπερματικό σωληνάριο έχει μία βασική μεμβράνη πάνω στην οποία επικάθονται τα σπερματικά κύτταρα (semineferous cells) και τα κύτταρα του Sertoli. Μεταξύ των σωληναρίων υπάρχει χαλαρός συνδετικός ιστός, που περιέχει τα κύτταρα του Leydig. Οι όρχεις εξυπηρετούν δύο λειτουργίες, την παραγωγή σπέρματος και ανδρικών ορμονών, των ανδρογόνων, με πρώτη την τεστοστερόνη.
Η Επιδιδυμίδα
Η επιδιδυμίδα είναι ένας σωλήνας που στο σχήμα μοιάζει με το κόμμα της στίξης, δίνει την εντύπωση συμπαγούς οργάνου με κεφαλή και βρίσκεται προσκολλημένη στην πίσω πλευρά του όρχεως .Η άκρη καθεμιάς αποτελεί συνέχεια του αντίστοιχου σπερματικού πόρου.
Μέσα από το λεπτό αυτόν πόρο τα σπερματοζωάρια, που παράγονται στους όρχεις, μεταφέρονται στην επιδιδυμίδα όπου και αποθηκεύονται. Η επιδιδυμίδα είναι ένα περιελιγμένο σωληνάριο, το οποίο τεντωμένο φτάνει τα πέντε με επτά μέτρα(εικ.2).

Εικόνα 2: H Eπιδιδυμίδα
Ετσι, ο σπερματικός πόρος μεταφέρει σπέρμα μέσα από το σπερματικό τόνο του όρχεως στην πύελο. Κάθε πόρος επεκτείνεται πίσω από την ουροδόχο κύστη και εκεί ενώνεται με τον αγωγό μιας σπερματοδόχου κύστης, σχηματίζοντας έναν αγωγό εκσπερμάτωσης. Οι δύο αυτοί αγωγοί περνούν μέσα από τον προστάτη και την ουρήθρα. Καθεμία από τις δύο σπερματοδόχους κύστες περιέχει δύο έως τρία χιλιοστά του λίτρου παχύρρευστο υγρό -μέρος του σπέρματος- όπου τρέφονται και «κολυμπούν» τα σπερματοζωάρια.